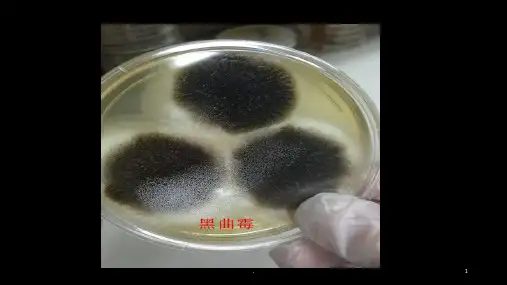

曲霉形态特征
- 格式:doc
- 大小:906.00 KB
- 文档页数:9

几种曲霉的形态特征常见曲霉菌鉴定:菌落:菌落生长速度,表面质地、颜色、形态和气味等。
其中颜色是曲霉菌分类的依据之一②分生抱子头:分生抱子头的形状、颜色和大小。
分生抱子头由顶囊、瓶梗、梗基和分生抱子链组成,为曲霉的特征性结构③分生抱子梗或分生抱子柄:注意分生抱子梗的长短、颜色、表面粗糙或光滑、是否有隔等④具有性生殖的曲霉能产生闭囊壳:为封闭式的薄壁子囊果,含子囊和子囊抱子;⑤足细胞,也为曲霉的特征性结构。
1、烟曲霉困在SDA培养基上菌落生长快,棉花样,开始为白色,2~3天后转为绿色,数日后变为深绿色,呈粉末状。
分生抱子头的顶囊烧瓶状,小梗单层,排列成木栅状,布满顶囊表面3/4 ,顶端有链形分生抱子,分生抱子球形,有小棘,绿烟曲霉菌菌落2、黄曲霉菌在SDA培养基上菌落生长快,黄色,表面粉末状。
分生抱子头顶囊球形或近球形,小梗双层,第一层长,布满顶囊表面,呈放射状排列,黄色,顶端有链形抱子黄曲霉菌菌落黄曲霉菌分生抱子头3、土曲霉困在SDA培养基上菌落生长快,小,圆形,淡褐色或褐色。
分生抱子头的顶囊半球形,小梗双层,第一层短,第二层长,呈放射状排列,分布顶囊表面2/3,顶端有链形抱子土曲霉菌落F列图片为分生抱子头4、黑曲霉困在SDA培养基上菌落生长快,表面黑色,粉末状。
分生抱子头的顶囊球形或近球形,小梗双层,第一层粗大,第二层短小,呈放射状排列,布满整个顶囊,黑色,顶端有链形抱子黑曲霉菌洛黑曲霉分生抱子头5、杂色曲霉困在SDA培养基上菌落生长慢,菌落圆形紧密,绒毛状,羊毛状,颜色有数环,从青绿到红绿。
分生抱子头的顶囊近球形,小梗双层,第一层长,第二层短, 呈放射状排列,布满顶囊4/5 ,顶端有链形抱子杂色曲霉菌菌落杂色曲霉菌分生抱子头下图为杂色曲霉菌分生抱子头电镜。




几种曲霉的形态特征常见曲霉困鉴定:菌落:菌落生长速度,表面质地、颜色、形态和气味等。
其中颜色是曲霉菌分类 的依据之一② 分生抱子头:分生抱子头的形状、颜色和大小。
分生抱子头由顶囊、瓶梗、梗 基和分生抱子链组成,为曲霉的特征性结构③ 分生抱子梗或分生抱子柄:注意分生抱子梗的长短、颜色、表面粗糙或光滑、 是否有隔等1、烟曲霉困在SDA 培养基上菌落生长快,棉花 样,开始为白色,2~3天后转为绿 色, 数日后变为深绿色,呈粉末 状。
分生抱子头的顶囊烧瓶状,小 梗单层,排列成 木栅状,布满顶囊 表面3/4,顶端有链形分生抱子,分生抱子球形,有小棘, 绿色烟曲霉菌菌落2、黄曲霉菌④ 具有性生殖的曲霉能产生闭囊壳:为封闭式的薄壁子囊果,含子囊和子囊抱子; ⑤足细胞,也为曲霉的特征性结构。
曲霉菌的结构在SDA培养基上菌落生长快,黄色,表面粉末状。
分生抱子头顶囊球形或近球形,小梗双层,第一层长,布满顶囊表面,呈放射状排列,黄色,顶端有链形抱子黄曲霉菌菌落黄曲霉菌分生抱子头3、土曲霉困在SDA培养基上菌落生长快,小,圆形,淡褐色或褐色。
分生抱子头的顶囊半球形,小梗双层,第一层短,第二层长,呈放射状排列,分布顶囊表面2/3,顶端有链形抱子土曲霉菌落F列图片为分生抱子头4、黑曲霉困在SDA培养基上菌落生长快,表面黑色,粉末状。
分生抱子头的顶囊球形或近球形,小梗双层,第一层粗大,第二层短小,呈放射状排列,布满整个顶囊,黑色,顶端有链形抱子黑曲霉菌洛黑曲霉分生抱子头5、杂色曲霉困在SDA培养基上菌落生长慢,菌落圆形紧密,绒毛状,羊毛状,颜色有数环,从青绿到红绿。
分生抱子头的顶囊近球形,小梗双层,第一层长,第二层短, 呈放射状排列,布满顶囊4/5 ,顶端有链形抱子杂色曲霉菌菌落杂色曲霉菌分生抱子头下图为杂色曲霉菌分生抱子头电镜。

曲霉的形态特征
曲霉(Aspergillus)是一种真菌,常见于自然环境中的土壤、
植物、腐木以及生物分解物中。
其形态特征如下:
1. 子实体:曲霉产生的子实体为顶生或侧生的固态菌核,由许多短小的分生孢子(conidia)组成,呈银灰色或淡黄色。
2. 菌丝体:曲霉的菌丝体呈无色或浅色,以立体网状结构排列,有分枝。
菌丝通常为一根或多根,呈现出纵向或斜向生长。
3. 墨盘层:曲霉的墨盘层为菌丝网络中的刺盘状结构,位于固体培养基的上表面。
墨盘层通常呈现黑褐色,但在某些物种中也可能是淡黄色或深棕色。
4. 菌落:曲霉菌落呈直径2-10cm的圆形或不规则形状,表面
平滑或有细纹。
菌落的颜色因不同物种而异,可以是白色、黄色、淡绿色、淡褐色或深绿色等。
5. 分生孢子:曲霉的分生孢子呈椭圆形或卵圆形,一般具有光滑的表面。
颜色通常为无色或浅色,但在某些物种中也可能是深色或有颜色斑点。
需要注意的是,曲霉存在着丰富的物种多样性,不同物种的形态特征会有所差异。
因此,在进行曲霉的形态鉴定时,需要结合其他的形态特征以及分子生物学方法来进行综合分析。

曲霉的名词解释曲霉,又被称为麦角菌,是一种常见的真菌种类,属于子囊菌门,拥有许多物种。
曲霉广泛分布于自然界中,可寄生于不同的植物和其他有机物上。
它以其独特的形态和生理特性而闻名,且有着重要的生物学和生态学意义。
一、曲霉的分类和特征曲霉有多个不同的物种,其形态特征和生态特性也存在差异。
一些常见的曲霉物种包括温带曲霉(Aspergillus ustus)、黄曲霉(Aspergillus flavus)、绿曲霉(Aspergillus niger)等。
曲霉的特点是具有典型的菌丝体结构。
菌丝体是由许多细长丝状细胞组成的,分为分枝和无分枝两种形态。
曲霉的菌丝体生长迅速,能够迅速适应环境中的条件。
二、曲霉的生态学和生物学意义1. 曲霉的分解作用曲霉是自然界中重要的分解者之一。
它们能够分解死物体和有机废料,将其转化为更简单的化合物,如二氧化碳、水和营养物质。
曲霉的分解作用对于循环营养物质的流动和生态平衡具有重要意义。
2. 曲霉的产物和应用曲霉可以产生多种代谢产物,其中一些具有广泛的应用价值。
例如,黄曲霉可以产生类黄酮毒素,对于食物产生污染和致病的影响。
另一方面,曲霉中的某些菌株具有产生酶的能力,可以应用于工业生产中的发酵和酶促反应。
3. 曲霉的致病性尽管曲霉在自然界中具有重要的生态功能,但某些曲霉物种也具有潜在的致病性。
例如,温带曲霉在人体内感染时,可能引发严重的感染和疾病,甚至导致死亡。
此外,曲霉还可以引起动物和植物的疾病,给农业和畜牧业带来危害。
三、曲霉的生长条件和预防措施曲霉在适宜的环境条件下生长迅速。
首先,曲霉需要湿度较高的环境,因此在潮湿的地方容易滋生曲霉。
其次,温度也是曲霉生长的重要因素,一般较适合的生长温度为20℃至30℃之间。
为了预防曲霉的滋生和散播,以下是一些常见的预防措施:1. 保持室内环境通风和干燥,尤其是在潮湿的季节或地区。
2. 定期清洁和消毒潮湿地区,如浴室、厨房和地下室。
3. 检查和修复可能导致潮湿的问题,如漏水管道和渗漏的屋顶。

曲霉青霉根霉的形态特征
1. 曲霉(Aspergillus):曲霉是一种拥有分枝孢子的真菌,它的形态特征包括:
- 菌丝体呈白色,细长且柔软,有时可分枝形成菌丝网络。
- 孢子堆为灰色或绿色,呈球形,并覆盖在特殊的菌丝结构上,称为菌柄。
- 孢子堆在成熟后会逐渐开裂,释放出大量孢子。
2. 青霉(Penicillium):青霉是一种以蘑菇状孢子团为特征的真菌,它的形态特征包括:
- 菌丝体呈蓝绿色或绿色,细长且有分枝。
- 孢子团为蓝绿色或绿色,有时呈黄色或白色,具有菌丝结构的圆顶。
- 孢子团上有许多小的圆柱状或球状孢子,被特殊的结构包裹。
3. 根霉(Rhizopus):根霉是一种以根状菌丝和黑色孢子团为特征的真菌,它的形态特征包括:
- 菌丝体呈白色或灰白色,密集地分布在基质上,形成有粗细不一的根状结构。
- 孢子团为黑色或暗褐色,通常生长在菌丝的末端,具有密集的球形结构。
- 孢子团上有许多小的圆柱状或球状孢子,被特殊的结构包裹。
根据上述的形态特征,可以通过显微镜观察来鉴定曲霉、青霉和根霉。

曲霉菌的形态特征
曲霉菌(Aspergillus)是一种真菌,可通过不断生长和分化形成分枝菌丝。
它们是世界上最常见的真菌之一,在大自然中广泛分布。
曲霉菌是革兰氏阳性菌,菌丝呈长柄状,顶端具有特殊的菌柄,轻微地分叉成几个方向,形成黑色、棕色或淡色子囊菌。
曲霉菌的形态特征如下:
1. 菌丝:曲霉菌体壁由无色的菌丝组成,菌丝壁发达,可防止外界环境的进入,保护菌体。
菌丝由单个细胞组成,长1-10微米,直径约1-3微米。
菌丝生长缓慢,但菌落形成后生长迅速。
2. 菌柄:曲霉菌菌柄是其特殊的形态特征之一,菌柄是一根圆柱形的细长结构,在顶端形成菌囊或芽胞。
菌柄长约50-200微米,直径约1-4微米。
3. 菌囊:曲霉菌的菌囊呈圆柱形或八角形,通常由单个菌丝顶端的菌柄形成。
菌囊内部含有芽胞,芽胞会分裂成多个孢子,孢子具有很高的耐受性,可以在干燥的环境中存活很长时间。
4. 孢子:曲霉菌的孢子较小,呈半球形或圆形,颜色多为黄色、绿色或棕色,直径约2-10微米。
每个菌囊内可生成数百个孢子,孢子形成迅速,可在1-2周内形成完整的孢子囊。
5. 菌落:曲霉菌的菌落呈现典型的酵母菌落形态,表面呈白色或灰色,质地柔
软,菌落下部为黄褐或灰黑色。
菌落的形态受到温度、湿度和营养状况等因素的影响。
总之,曲霉菌具有明显的真菌特征,其生长特点、形态特征和生命周期等方面都是学术研究的重点,这些知识不仅在食品工业、医学和环境监测方面具有重要意义,也有助于人们更好地理解生物体的形态和生命活动。

霉菌的形态观察一、实验目的1.学习井掌握观察靈菌形态的基本方法:2.了解常见篷菌(根惩、毛稳、曲霉、青鑫、红曲霉、白地签)的基本形态特征。
二、实验材料1.菌种:根殆(Rhizopus sp.)毛霉(Mucor sp.)曲殆(.Aspergillus sp.)青签(Penicillium sp.)、红曲霉(Monascus sp.)的平板培养物,白地殆(Geotrichum candidum)摇瓶培养液。
2.培养基:上豆琼脂培养基(PDA)或察氏培养基。
3.溶液或试剂:乳酸石炭酸棉蓝染色液。
4.其他:无菌吸管,平皿,载玻片,盖玻片,解剖针,显微镜等。
三、实验原理霉菌菌丝比较粗大(菌丝和抱子的直径达到3-10um),通常是细菌菌体宽度的几倍至几十倍,因而可用低倍、高倍镜观察。
靈菌菌丝细胞容易收缩变形,抱子容易飞扬,在制备霉菌标本时,常用乳酸石炭酸溶液作为介质,具有不使细胞变形,可杀菌防腐,不易干燥, 能保持较长时间等优点。
若加入棉蓝,又具有一定的染色效果。
霉菌的有些结构在制片过程中易被破坏,影响观察,可采用载片培养法。
此法便于直接在显微镜下观察,尤其适用于根霉的假根、曲爲的足细胞及分生抱子链等结构的着生和生长情况的观察。
并且还可以在同一标本上观察到微生物发育的不同阶段的形态。
四、操作步骤(-)一般观察法:1.点种培养:用接种针沾取斜而少许泡子在无菌的察氏培养基中央穿刺接种(倒置培养皿穿刺接种),30'C下培养7~10天,形成巨大菌落培养物。
2.直接制片:在载玻片中央加一滴乳酸石炭酸棉蓝染色液于洁净,打开監菌平板培养物, 用解剖针从菌落的边缘挑取少量带有砲子的菌丝,放入载玻片的染液中,细心地把菌线挑散开,加盖玻片,注意不要产生气泡,置于显微镜下观察,菌丝呈兰色,颜色的深度随菌龄的增加而减弱。
观察根霉时,注意观察貝菌丝有无横隔、假根、抱子囊柄、抱子囊、囊轴、囊托、泡子囊砲子及厚垣抱子。
观察毛霉时,注意观察其菌丝无横隔、抱子囊柄、囊轴、抱子囊泡子及后垣抱子。
根霉曲霉青霉的形态特征嘿,朋友们,今天咱们来聊聊根霉、曲霉和青霉这几个微生物界的“小居民”。
先说说根霉吧,这根霉就像个长着好多小脚丫的怪家伙。
你看它,白色的菌丝就像毛茸茸的小毯子,在合适的环境里肆意蔓延。
它的假根就像是扎进土地里的小锚,紧紧地抓住底物,就像生怕被一阵风吹跑似的。
根霉就像是微生物界里的小顽固,只要找到地方就拼命扎根,而且繁殖速度快得像一阵旋风,一下子就能占领一大片“地盘”呢。
再看看曲霉,曲霉可有趣了。
它的菌丝像是错综复杂的小迷宫,弯弯曲曲的,让人眼花缭乱。
曲霉的孢子梗就像一个个小烟囱,顶端还顶着个像小帽子一样的顶囊。
这顶囊上长满了孢子,就像是小烟囱里冒出来的黑烟,只不过这黑烟是曲霉用来繁衍后代的孢子罢了。
曲霉就像是个微观世界里的小建筑师,精心构建着自己独特的结构,而且还特别爱“显摆”自己那独特的造型,在显微镜下看就像个小小的艺术作品。
最后就是青霉啦。
青霉就像穿着绿衣服的小魔法师。
它那绿色的孢子就像是洒在白色菌丝上的小绿点,就像星星点点的绿宝石。
青霉的菌丝形态也很奇特,有的像树枝一样分叉开来,感觉像是在微观世界里种了一棵小绿树。
青霉还有股子神秘的劲儿,就像个隐藏在角落里的小隐士,默默地做着自己的事情,但是又有着不可忽视的存在。
这三个小家伙虽然都是霉菌,但它们各有各的特点。
根霉像个执着的拓荒者,曲霉像个搞怪的艺术家,青霉像个神秘的小仙人。
有时候它们在我们的生活里捣乱,比如让食物发霉变质。
但有时候呢,它们又能发挥大作用,就像青霉可以用来制造青霉素,拯救了无数的生命,这时候它们又像是超级英雄一样伟大。
它们在微观世界里就像三个性格迥异的小伙伴,每天都在上演着自己的故事。
虽然我们肉眼很难看清它们的全貌,但在显微镜下看到它们那奇特的形态时,就像发现了一个全新的小世界,充满了惊喜和奇妙的想象。
下次当你看到食物上有霉菌的时候,可别光想着厌恶,也可以想象一下这些小家伙们独特的模样和有趣的“生活”哦。
真菌的个体和菌落形态特征
真菌是一类复杂多样的生物体,其个体和菌落形态特征有着很大的差异性。
在个体形态方面,真菌分为单细胞真菌和多细胞真菌两大类。
单细胞真菌包括酵母菌等,其个体为单个细胞,呈球形或卵圆形,大小一般在 1-10 微米之间。
多细胞真菌包括很多种类的真菌,如黑曲霉、青霉等,其个体由许多细胞组成,形成不同形态的菌丝体、子实体等。
在菌落形态方面,真菌也表现出了很大的变异性。
菌落是指真菌在培养基上生长成的一团群体,其形态和颜色等特征可以帮助鉴定真菌种类。
不同种类的真菌在培养基上形成的菌落也有着不同的特征。
如青霉菌的菌落形态呈覆盖整个培养基的绿色毛状,而曲霉菌的菌落呈灰绿色平整的菌丝网状。
总的来说,真菌的个体和菌落形态特征是其种类鉴定的重要依据,也是了解真菌生命活动的重要途径之一。
- 1 -。
灰绿曲霉菌落特征
嘿,朋友们!今天咱来聊聊灰绿曲霉菌落特征。
你看啊,这灰绿曲霉菌落就像是一个小小的神秘世界。
它的颜色呢,就如同它的名字一样,带着那种有点特别的灰绿色。
想象一下,那颜色就好像是大自然中一片独特的苔藓,不张扬却有着自己的个性。
它的形态呢,也是很有特点的哟!有的时候看起来像是一朵朵迷你的云朵,飘浮在培养基上;有的呢又像是一个个小小的山丘,起起伏伏的。
这多有意思呀!
说到它的质地,就好像是一块柔软的绒布,摸上去可能还会有一点点的弹性呢。
可别小瞧了这看似普通的质地,里面可藏着不少秘密呢!
它的生长速度呢,说快不快,说慢也不慢。
就像是一个慢性子的小朋友,不慌不忙地在自己的小天地里成长着。
有时候你会发现,过了一段时间再去看它,哟呵,它又有了新的变化。
你说这灰绿曲霉菌落是不是很神奇呀?它虽然小小的,但是却有着自己独特的魅力。
就好像我们生活中的很多小事物一样,看似不起眼,实则有着大乾坤。
我们在观察它的时候,就像是在探索一个未知的领域。
每一个细节,每一个变化,都能给我们带来惊喜。
这难道不是很有趣吗?
它就像是大自然给我们的一个小礼物,等待着我们去发现,去了解。
我们可以通过它来更好地理解微生物的世界,感受这个世界的奇妙之处。
所以啊,别小看了这灰绿曲霉菌落,它可是有着很多值得我们去探究的地方呢!它就像是一个隐藏在微观世界里的宝藏,等待着我们去挖掘,去发现它的美,它的独特之处。
让我们一起用心去感受它吧!。
曲霉的分离曲霉是一种真菌,广泛存在于自然界中的土壤、水体和空气中。
它们具有很强的代谢能力,可以分解有机物质,是生物降解和有机废弃物处理的重要微生物。
此外,曲霉还可以产生一些重要的代谢产物,如抗生素、酶、有机酸等,在食品工业、医药工业、环境保护等领域具有广泛应用。
曲霉的分离是研究其代谢特性和产物合成机制的基础。
以下是关于曲霉分离的详细介绍:1. 分离方法(1)土壤样品法:从自然环境中采集土壤样品,将其加入含有适当营养成分的琼脂培养基中,在适当温度下培养并筛选出曲霉菌株。
(2)空气样品法:采用空气采样器采集室内或室外空气中的微生物样品,将其接种到含有适当营养成分的琼脂培养基中,在适当温度下培养并筛选出曲霉菌株。
(3)食品样品法:从食品中采集曲霉样品,将其接种到含有适当营养成分的琼脂培养基中,在适当温度下培养并筛选出曲霉菌株。
2. 培养条件曲霉的生长和代谢需要适宜的温度、湿度和营养物质。
通常情况下,曲霉的最适生长温度为25℃-30℃,最适生长pH值为5.0-7.0。
在培养基中添加合适的碳源、氮源和矿物质元素可以促进曲霉菌株的生长和代谢。
3. 筛选方法在分离得到曲霉菌株后,需要进行筛选以获得具有特定代谢特性或产物合成能力的菌株。
常用的筛选方法包括:(1)形态学特征:通过观察菌落形态、颜色、纹理等特征来鉴定不同种类的曲霉菌株。
(2)抗生素活性:利用抑制其他微生物生长的能力来筛选具有抗生素活性的曲霉菌株。
(3)酶活性:利用曲霉产生的酶来分解特定底物,通过观察底物的降解情况来筛选具有特定酶活性的曲霉菌株。
(4)代谢产物:通过检测曲霉菌株发酵液中的代谢产物来筛选具有特定代谢能力的曲霉菌株。
4. 保存方法分离得到的曲霉菌株需要进行保存以便后续研究。
常用的保存方法包括:(1)冷冻法:将曲霉菌株培养在含有10%-20%甘油或DMSO的琼脂培养基上,将其置于-80℃低温条件下保存。
(2)干燥法:将曲霉菌株培养在琼脂培养基上,将其置于干燥器中进行干燥处理,然后将其保存在低温、低湿度条件下。
几种曲霉的形态特征
常见曲霉菌鉴定:
菌落:菌落生长速度,表面质地、颜色、形态和气味等。
其中颜色是曲霉菌分类的依据之一
②分生孢子头:分生孢子头的形状、颜色和大小。
分生孢子头由顶囊、瓶梗、梗基和分生孢子链组成,为曲霉的特征性结构
③分生孢子梗或分生孢子柄:注意分生孢子梗的长短、颜色、表面粗糙或光滑、是否有隔等
④具有性生殖的曲霉能产生闭囊壳:为封闭式的薄壁子囊果,含子囊和子囊孢子;
⑤足细胞,也为曲霉的特征性结构。
曲霉菌的结构
1、烟曲霉菌
在SDA培养基上菌落生长快,棉花样,开始为白色,2~3天后转为绿色,数日后变为深绿色,呈粉末状。
分生孢子头的顶囊烧瓶状,小梗单层,排列成木栅状,布满顶囊表面3/4,顶端有链形分生孢子,分生孢子球形,有小棘,绿色
烟曲霉菌菌落
2、黄曲霉菌
在SDA培养基上菌落生长快,黄色,表面粉末状。
分生孢子头顶囊球形或近球形,小梗双层,第一层长,布满顶囊表面,呈放射状排列,黄色,顶端有链形孢子
黄曲霉菌菌落
黄曲霉菌分生孢子头
3、土曲霉菌
在SDA培养基上菌落生长快,小,圆形,淡褐色或褐色。
分生孢子头的顶囊半球形,小梗双层,第一层短,第二层长,呈放射状排列,分布顶囊表面2/3,顶端有链形孢子
土曲霉菌落
下列图片为分生孢子头
4、黑曲霉菌
在SDA培养基上菌落生长快,表面黑色,粉末状。
分生孢子头的顶囊球形或近球形,小梗双层,第一层粗大,第二层短小,呈放射状排列,布满整个顶囊,黑色,顶端有链形孢子
黑曲霉菌落
黑曲霉分生孢子头
5、杂色曲霉菌
在SDA培养基上菌落生长慢,菌落圆形紧密,绒毛状,羊毛状,颜色有数环,从青绿到红绿。
分生孢子头的顶囊近球形,小梗双层,第一层长,第二层短,呈放射状排列,布满顶囊4/5,顶端有链形孢子
杂色曲霉菌菌落
杂色曲霉菌分生孢子头
下图为杂色曲霉菌分生孢子头电镜。